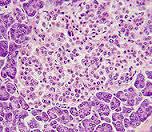

Инсулинома
Инсулинома является разновидностью опухоли, выделяющей больше количество инсулина, в результате чего у больного развиваются приступы гипогликемии, обусловленные низким содержанием сахара в сыворотке крови.
Инсулинома является разновидностью опухоли, выделяющей больше количество инсулина, в результате чего у больного развиваются приступы гипогликемии, обусловленные низким содержанием сахара в сыворотке крови.
Наиболее часто инсулинома развивается в поджелудочной железе, но известны случаи ее развития в печени и кишечнике.
Для инсулиномы характерно возрастное развитие. Ею в большей мере страдают люди в возрастном промежутке от 25 до 50 лет, т.е. трудоспособное население планеты. В детском и подростковом возрасте заболевание появляется в исключительном случае. Инсулинома поджелудочной железы в 95% случаев развивается в виде доброкачественной опухоли. В ряде эпизодов инсулинома служит признаком множественного эндокринного аденоматоза – предракового состояния.
Механизм развития гипогликемии при инсулиноме
В основном инсулинома располагается в хвосте, головке или теле поджелудочной железы и лишь иногда локализуется в печени, воротах, сальнике селезенки, стенке желудка и двенадцатиперстной кишке. Размеры инсулиномы обычно не превышают 2 см.
Опухолевые b-клетки инсулиномы бесконтрольно секретируют инсулин в избыточном количестве. Инсулин снижает уровень содержания глюкозы в крови, и создаются условия для возникновения гипогликемического синдром.
В большей мере страдают от этого клетки головного мозга, для которых глюкоза является основным питательным веществом его жизнедеятельности. И в случае значительного снижения уровня глюкозы повреждаются нейроны головного мозга. В результате нарушения снабжения мозга глюкозой возникает нейрогликопения, а длительно текущая гипогликемия при инсулиноме вызывает дистрофические изменения центральной нервной системы.
Состояние гипогликемии способствует выбросу в кровь кортизола, глюкагона, соматотропина и норадреналина. Повышенное содержание этих гормонов развивает адренергическую симптоматику, т.е. обусловленную компенсаторной активацией вегетативной нервной системы. Кроме того при развитии дистрофии центральной нервной системы возникают нейрогликопенические симптомы гипогликемии.
Симптомы инсулиномы
Как говорилась выше, симптомы инсулиномы выражаются проявлением приступов гипогликемии. Появляется общая слабость, потливость и тахикардия. Все это сопровождается беспокойством, раздражительностью и страхами. На фоне развития приступа пациенты испытывают жгучее чувство голода. Прием пищи сразу снимает симптоматику. В связи с этим многие пациенты страдают ожирением.
Наиболее тяжело протекает инсулинома, со слабо выраженной или вовсе отсутствующей симптоматикой. Это связано с невозможностью ориентироваться в своевременности принятия пищи и восполнением глюкозы в крови.
Нейрогликопенические симптомы выражаются снижением концентрации внимания, нарушением мышечного тонуса, головной болью. У больного появляются неадекватность и дезориентация, спутанность сознания, очень яркие и образные галлюцинации. Нередко происходит частичная амнезия, зрительные и речевые нарушения.
Дальнейшее снижение уровня содержания глюкозы приводит к судорогам, параличу и нередко к коме.
В период приступа человек бесконтрольно может быть агрессивным к окружающим при попытке отобрать для себя продукты.
Мышечный тонус повышается, нередко возникает эпилептический припадок. При этом учащается сердцебиение, расширяются зрачки и повышается артериальное давление. При несвоевременно оказанной медицинской помощи больной может впасть в гипогликемическую кому. В коматозном состоянии человек теряет сознание, расширяются зрачки, прекращается потоотделение и снижается мышечный тонус. Падает артериальное давление, происходит нарушение сердечного и дыхательного ритма. Нередко у больного в коме происходит отек головного мозга.
Если ставиться диагноз инсулинома, то родные и близкие больного должны знать о способах снятия состояния гипогликемии и в случае непроходящего приступа немедленно обращаться за медицинской помощью.
При часто возникающих гипогликемических комах может развиться судорожный синдром, паркинсонизм и дисциркуляторная энцефалопатия.
Диагностика инсулиномы
Установить диагноз инсулиномы довольно трудно. Для эффективности диагностики инсулиномы пациента с подозрением на развитие опухоли госпитализируют и проводят обследование при голодании в течение 24-72 часов.
Проводится исследование крови на содержание в ней уровня инсулина и глюкозы. Характерными показателями при этом являются значительно повышенное содержание инсулина и низкая концентрация глюкозы.
Локализация инсулиномы определяется ультразвуковым исследованием, компьютерной или магнитно-резонансной томографией. В особых случаях проводится лапаротомия или лапароскопия.
 Лечение инсулиномы
Лечение инсулиномы
Радикальным лечением инсулиномы является ее хирургическое удаление. Удаляют инсулиному в границах здоровых тканей. От оперативного вмешательства отказываются в случае тяжелых сопутствующих соматических заболеваний или при нежелании оперироваться самого пациента.
В случае злокачественного характера опухоли с множественными метастазами и невозможностью ее полного удаления проводится медикаментозная терапия с использованием препаратов подавляющих секрецию инсулина и снимающих тяжесть проявлений инсулиномы. Возможно применение глюкокортикоидов, но необходим контроль над уровнем кортизола.
Если операция не может быть выполнена, назначается консервативное лечение инсулиномы.
В консервативном лечение используется лекарственная терапия, направленная на улучшение в головном мозге обменных процессов и купирование приступов гипогликемии.
Экстренно купировать приступ можно с помощью горячего сладкого чая или конфеты. Если отмечается нарушение сознания, то необходимо внутривенное введение глюкозы. Если у больного развивается психоз или гипогликемическая кома, то необходимо срочно вызвать скорую медицинскую помощь.
